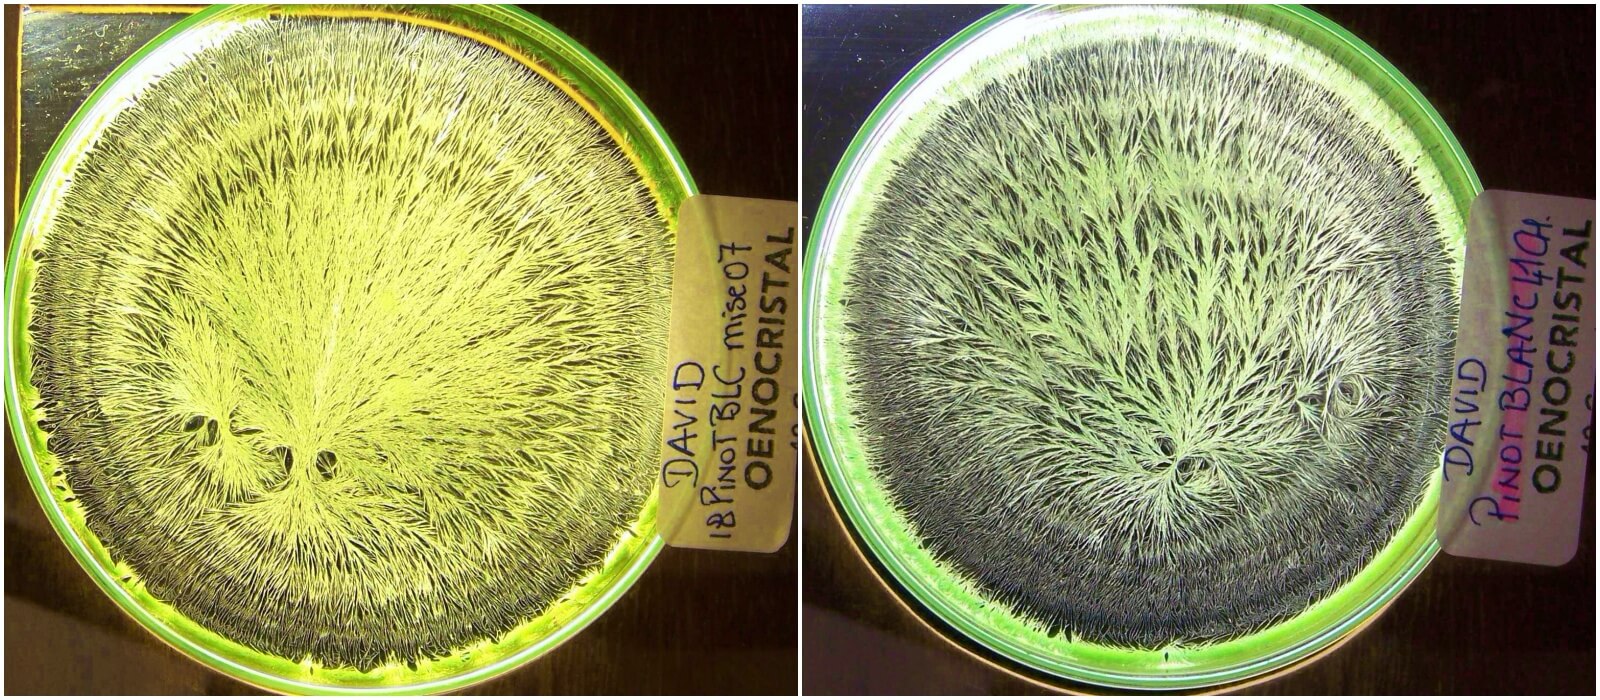

David Didon - Domaine Naima & David Didon
« Je pense qu’on se nourrit aussi par les yeux »
La passion, selon David et Naima, ne s’arrête pas simplement à la dégustation. Eux deux sont allés au bout de leur rêve, qu’ils considèrent plutôt comme un aboutissement. Le bout de paradis qu’ils ont trouvé se situe à Chassey le Camp. Bien que réputé pour son site archéologique, Chassey le Camp abrite aussi le tout jeune Domaine Didon, niché entre Santenay et Bouzeron, en Côte d’Or donc.
Oubliez les paysages souvent lunaires de certaines monocultures. Ici, des bois bordent les vignes, les prairies bordées de haies côtoient quelques cultures. David et Naima ont aussi plantés des fruitiers tout autour de leurs vignes. Un détail me diriez-vous ? Et bèh non, c’est justement tout sauf un détail. Comme le dit David, c’est cet environnement qui l’a conforté dans l’idée de s’installer sur cette commune. Cette diversité de paysages apporte une biodiversité très importante à l’équilibre de la vigne.

David est originaire d’Alsace où il a vécu jusqu’à l’âge de 20 ans. Un BTS en protection de l’environnement puis une spécialisation en biodynamie en poche, David n’était pas encore destiné à la culture de la vigne. Suite à son expérience en Côtes-de-Toul où il a pu mêler arboriculture et viticulture, David a compris que la vigne allait l’accompagner tout au long de sa vie.
Embauché au milieu des années 2000 comme chef de culture au Château de Puligny dans le but de convertir l’ensemble du vignoble en biodynamie, c’est au bout d’une dizaine d’années qu’il est parvenu à re(sentir) l’évolution des vignes.

En terme de pratiques culturales, David a naturellement choisi de mener la vigne en bio et biodynamie. Il a fallu remettre de la vie dans les sols car les vignes avaient été désherbées depuis une vingtaine d’années. Les vignes de Pinot Blanc, d’Aligoté et de Pinot Noir ont été plantées entre 1947 et 1962. Que de la vieille vigne, de la sélection massale… Le sol a réagi très vite grâce un apport de compost (fumier de vache et de poule) ainsi que des préparations biodynamiques. Une grosse utilisation de la 500 (préparation à base de bouse de vache, enterrée à l’automne et récupérée à Pâques) ont aussi permis de régénérer le sol et augmenter leur capacité à assimiler l’eau et ses nutriments.

Pour David, la biodynamie n’est pas simplement une technique agronomique. Il considère que cette pratique a une dimension ‘spirituelle’ qui est une façon de replacer le vivant au centre de la culture et du matérialisme qui est désormais la norme. « Comment activer et maitriser les forces que l’on ne perçoit pas forcément ?», c’est la grande question qui le mènera tout au long de sa vie de vigneron…
L’objectif a toujours été de produire des vins sans soufre, et toujours garder son âme de chercheur/observateur afin de comprendre au mieux ses cuvées. La biodynamie trouve ici tout son sens, notamment avec l’achillée (qui apporte la signature ‘soufre’ dans les vins) et la camomille, deux fleurs qui permettent, entre autre, de se passer de soufre pendant l’élevage.
Le pressurage est effectué à l’aide d’un vieux pressoir en bois vertical. Cela permet une extraction douce, pour les blancs comme pour les rouges. L’élevage se fait dans des pièces classiques Bourguignonnes de 228 litres ou en vieux foudres.
Des doses homéopathiques de soufre sont utilisées lors de l’élevage des vins, rouges comme blancs.
C’est en discutant avec Patrick Meyer, grand vigneron d’Alsace, qu’ils ont souhaité creuser le sujet dès la création du Domaine en 2017. Le soufre est donc dilué puis apporté au vin pour les informer à différents moments de leur vie (vinification, après fermentation malolactique et lors de la mise en bouteille). Margarethe Chapelle poursuit ce travail avec eux en proposant des cristallisations sensibles qui permettent d’interpréter ces images et d’observer certaines carences et l’évolution des vins dans le temps.
Nous continuons notre visite à la cave où nous avons la chance de goûter leurs bulles ainsi que leur vin rouge sur le millésime 2017. Ce dernier était une bombe de fruit, ça promet pour les prochains millésimes disponibles… A termes, leur idée serait de basculer sur un élevage plus long pour les rouges de l’ordre de 18 à 24 mois, et conserver un élevage de 12 mois pour les aligotés afin de « conserver leur fraicheur ». Et tout cela accompagné d’un délicieux repas préparé par Naima.

Nous avons recu ici une leçon d’humilité et de vie. Un échange hors du commun qui reflète la façon de travailler de David et Naima. Une approche sincère, belle, qui ouvre l’appétit et qui donne envie, encore et toujours, de découvrir leurs vins millésimes après millésimes.
Si vous souhaitez découvrir encore plus d’informations sur le Domaine Didon, n’hésitez pas à écouter notre podcast disponible juste ici :
Podcast ‘Domaine Naima & David Didon, par David Didon : « Je pense qu’on se nourrit aussi avec les yeux »
0’ : Introduction
0’52 : Présentation de David : son histoire, ses expériences…
4’40 : La conversion d’un vignoble en biodynamie : défis relevé par David !
7’38 : La reprise ou la création d’un domaine : les explications de MONSIEUR Didon
17’58 : Quels choix fais au domaine en termes de pratiques culturales ? Et l’importance de la biodynamie…
24’30 : Qu’est-ce que la biodynamie ?
33’32 : Quelle est l’approche de David par rapport au soufre ajouté dans les vins ? Et ses alternatives en biodynamie…
43’40 : Comment David a-t-il vécu le millésime caniculaire 2019 ?
45’17: Présentation des cuvées du domaine, et accords mets & vins
58’50: Quelle musique écouter avec les vins du domaine Didon ?
59’49 : Conclusion
